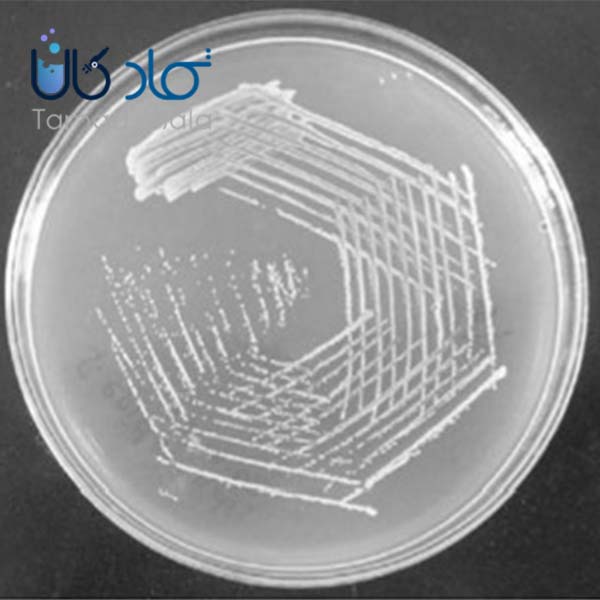
انواع محیط‌ های کشت باکتری

استاندارد 0.5 مک فارلند برای تخمین کدورت و میزان باکتری معلق در مایعات استفاده میشود. روش تهیه استاندارد مک فارلند از طریق مخلوط کردن کلرید باریوم 1%...

هر ماده شیمیایی صد در صد خالص نبوده و ناخالصی دارد. سود پرک نیز به عنون یک ماده شیمیایی حاوی ناخالصی است. سود پرک یکی از مواد بسیار کاربرد در صنایع مخ...
باکتری هم مثل هر موجود زنده دیگری، نیاز به محیط مناسب و مخصوصی دارد که بتواند در به حیات و بقا ادامه دهد. از جمله محیط های مناسبی که باکتری میتواند د...

مایعات با نقطه اشتعال کمتر از 60 درجه سانتی گراد (140 درجه فارنهایت) مواد شیمیایی قابل اشتعال در نظر گرفته می شوند. نقطه اشتعال یک ماده شیمیایی دمایی...

مقدمه: طرح اعتبار خرید مواد شیمیایی، ظروف، تجهیزات و خدمات آنالیز بدون نیاز به تسویه آنی، یکی از طرح های مصوب در شرکت توسعه مهندسی الماس واره دانش...

چسب ماده ای است که می تواند باعث چسبندگی دو جسم به یکدیگر شود این ساده ترین تعریف برای چسب است ما در این بخش به بررسی چسب نشاسته می پردازیم. شاید برای...

سختی چیست به مقاومت هر ماده در برابر تغییر شکل پلاستیک، سختی گفته می شود. سختی، میزان مقاومت سطح ماده در برابر تغییر شکل دائم یا پلاستیک است. از آنجا...

اسید سولفوریک مایعی شفاف، روغنی و بی بو (میزان بو بستگی به درجه خلوص دارد) با نام های سولفات هیدروژن و جوهر گوگرد و فرمول شیمیایی H2SO4 که دارای جرم...

مولاژ ها ماکت هایی هستند که برای مقاصد آموزشی در سنین مختلف استفاده میگردد. مولاژ به معنای قالب بوده و معمولا از فوم، لاتکس یا لاستیک ساخته میشود. م...

پرداخت طلا فرایندی است که در طی آن به منظور بالا بردن خواص سایشی طلا، سطح طلا توسط ماشین آلات به خصوص صاف، صیقلی و براق می شود. فرایند پرداخت طلا در...

اتوکلاو تشکیل شده از دو کلمه Auto به معنی خودکار و cave به معنی قفل شونده است و دستگاهی است که برای استریل کردن مورد استفاده قرار می گیرد. این دستگاه...

محیط کشت گزیلوز لیزین دزوکسی کولات آگار که به اختصار به آن XLD Agar گفته می شود، یک از محیط کشت های انتخابی و افتراقی است. pH تقربی این محیط 7.4 است...
مقالات مفید
